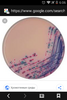
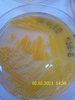

Больше информации по резюме будет доступно после регистрации
ЗарегистрироватьсяМужчина, 38 лет, родился 19 июня 1987
Москва, м. Аннино, готов к переезду (Московская область), готов к редким командировкам
Руководитель startup ( биомедицина, биотехнологии)
100 000 ₽ на руки
- Врач
Тип занятости: полная занятость, проектная работа/разовое задание
Опыт работы 11 лет 8 месяцев
Москва, big.gccit.ru/company/
Москва
Медицина, фармацевтика, аптеки... Показать еще
Москва, ru.swissmedica.org/
Медицина, фармацевтика, аптеки... Показать еще
Одинцово (Московская область), www.kolbasa.ru
Продукты питания... Показать еще
Мексика, m.facebook.com/clinicamedicaydentalrio/
Медицина, фармацевтика, аптеки... Показать еще
Россия, deyev-lab.ru/
Медицина, фармацевтика, аптеки... Показать еще
Москва, spectrumlab.ru/,http://http://mlounge.ru/
Медицина, фармацевтика, аптеки... Показать еще
Москва, splast.ru,http://www.pram5.ru/
Медицина, фармацевтика, аптеки... Показать еще
Москва, proteogenex.com/
Медицина, фармацевтика, аптеки... Показать еще
Москва, www.biengi.ac.ru/expression.htm
Навыки
Обо мне
Высшее образование (Кандидат наук)
Знание языков
Повышение квалификации, курсы
Гражданство, время в пути до работы
Гражданство: Россия
Разрешение на работу: Россия
Желательное время в пути до работы: Не имеет значения